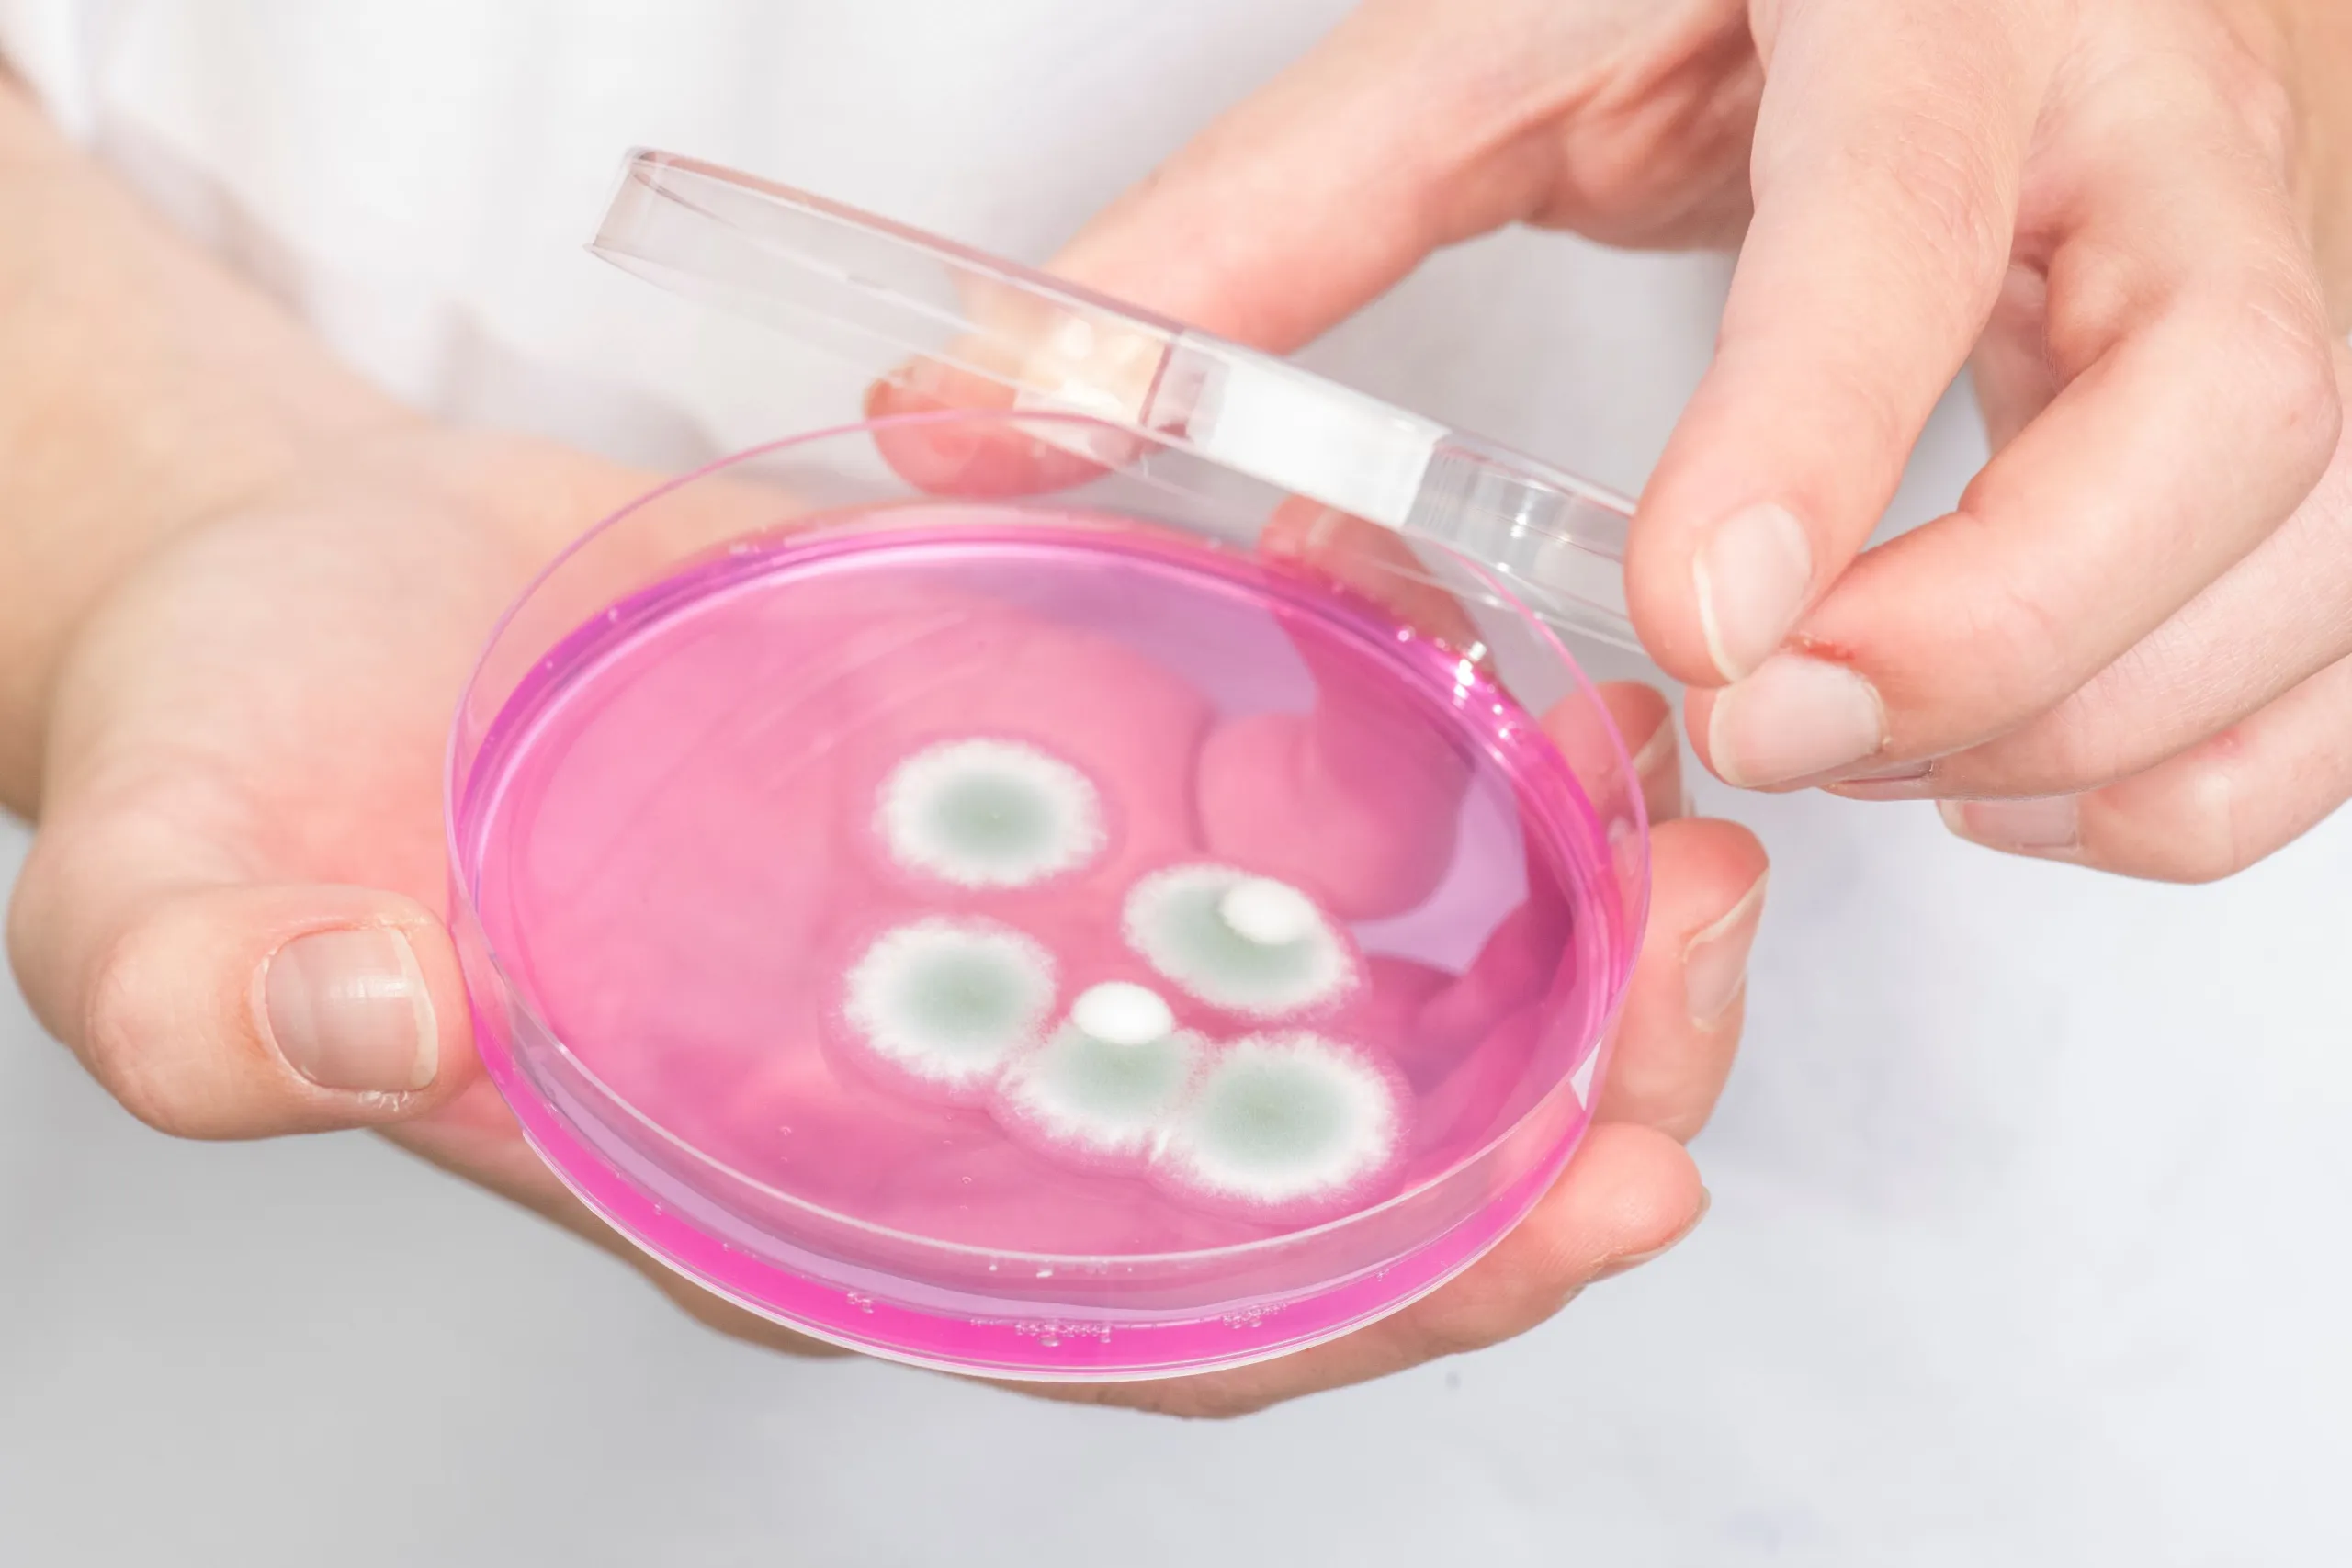

Produktion & Technik Waging
Unsere Bereiche und Teams:


Stephanie Gündogdu
ERP Specialist Production / PT Assistenz Käsereien
Stephanie.Guendogdu@bergader.de
+49 8681 404-503

Nadine Klöpping
ERP Specialist Production / PT Assistenz Käsereien
Nadine.Kloepping@bergader.de
+49 8681 404-504
Käserei 1

Unsere Käserei 1 ist Baujahr 1970. Wir produzieren hier in zwei Schichten unsere Blaukäsespezialitäten edelblu/Edelpilz und Bavaria blu – Der Würzige.
Käserei 2

In unserer Käserei 2 produzieren wir in drei Schichten unsere Weichkäsespezialitäten der Marken Bavaria blu, Bergbauern und Almzeit. Im Jahr ihrer Inbetriebnahme (2012) galt unsere Käserei 2 als modernste Weichkäserei Europas.
Verpackung

Die Verpackung ist unsere größte Abteilung. Hier werden unsere Käse in drei Schichten mit rund 130 Mitarbeitern zu 200 verschiedenen Artikeln abgepackt.
Technische Planung

In der technischen Planung werden alle Investitionen in neue Anlagen und Gebäude geplant und bis zur Inbetriebnahme betreut.
Auch das Planen der jährlichen Investitionen in Anlagen und Gebäude, die Verwaltung der Gebäudepläne sowie die Kommunikation mit Behörden (Bauamt, Wasserwirtschaftsamt, Immissionsschutz) gehört zu den Aufgaben des Teams der technischen Planung.
QS & Labor
Unser Team gewährleistet die Einhaltung strenger gesetzlicher Vorgaben durch ein umfassendes System von Hygiene- und Qualitätsrichtlinien.
Zusätzlich stellen wir mithilfe unseres QS-Teams durch umfangreiche Untersuchungen entlang der gesamten Produktionskette sicher, dass sowohl die Milch als auch unsere Käsespezialitäten stets den hohen Qualitätsstandards entsprechen.
Wareneingang

So erreicht ihr uns:
wareneingang-bpk@bergader.de
für allgemeine, nicht personenbezogene Themen, die den „Wareneingang BPK“ betreffen.

Service & Instandhaltung
Das SI-Team kümmert sich darum, dass alle Anlagen und Maschinen einwandfrei laufen. Die rund 40 Facharbeiter und mehrere Auszubildende warten und reparieren bei uns die gesamten technischen Anlagen in der Käserei und der Verpackung. Das beinhaltet auch Inspektion und Wartung.
Darüber hinaus betreut das Team den Bereich der Energieversorgung:
- Dampferzeugung
- Strom
- Wasser
- Abwasser
- Heizung

